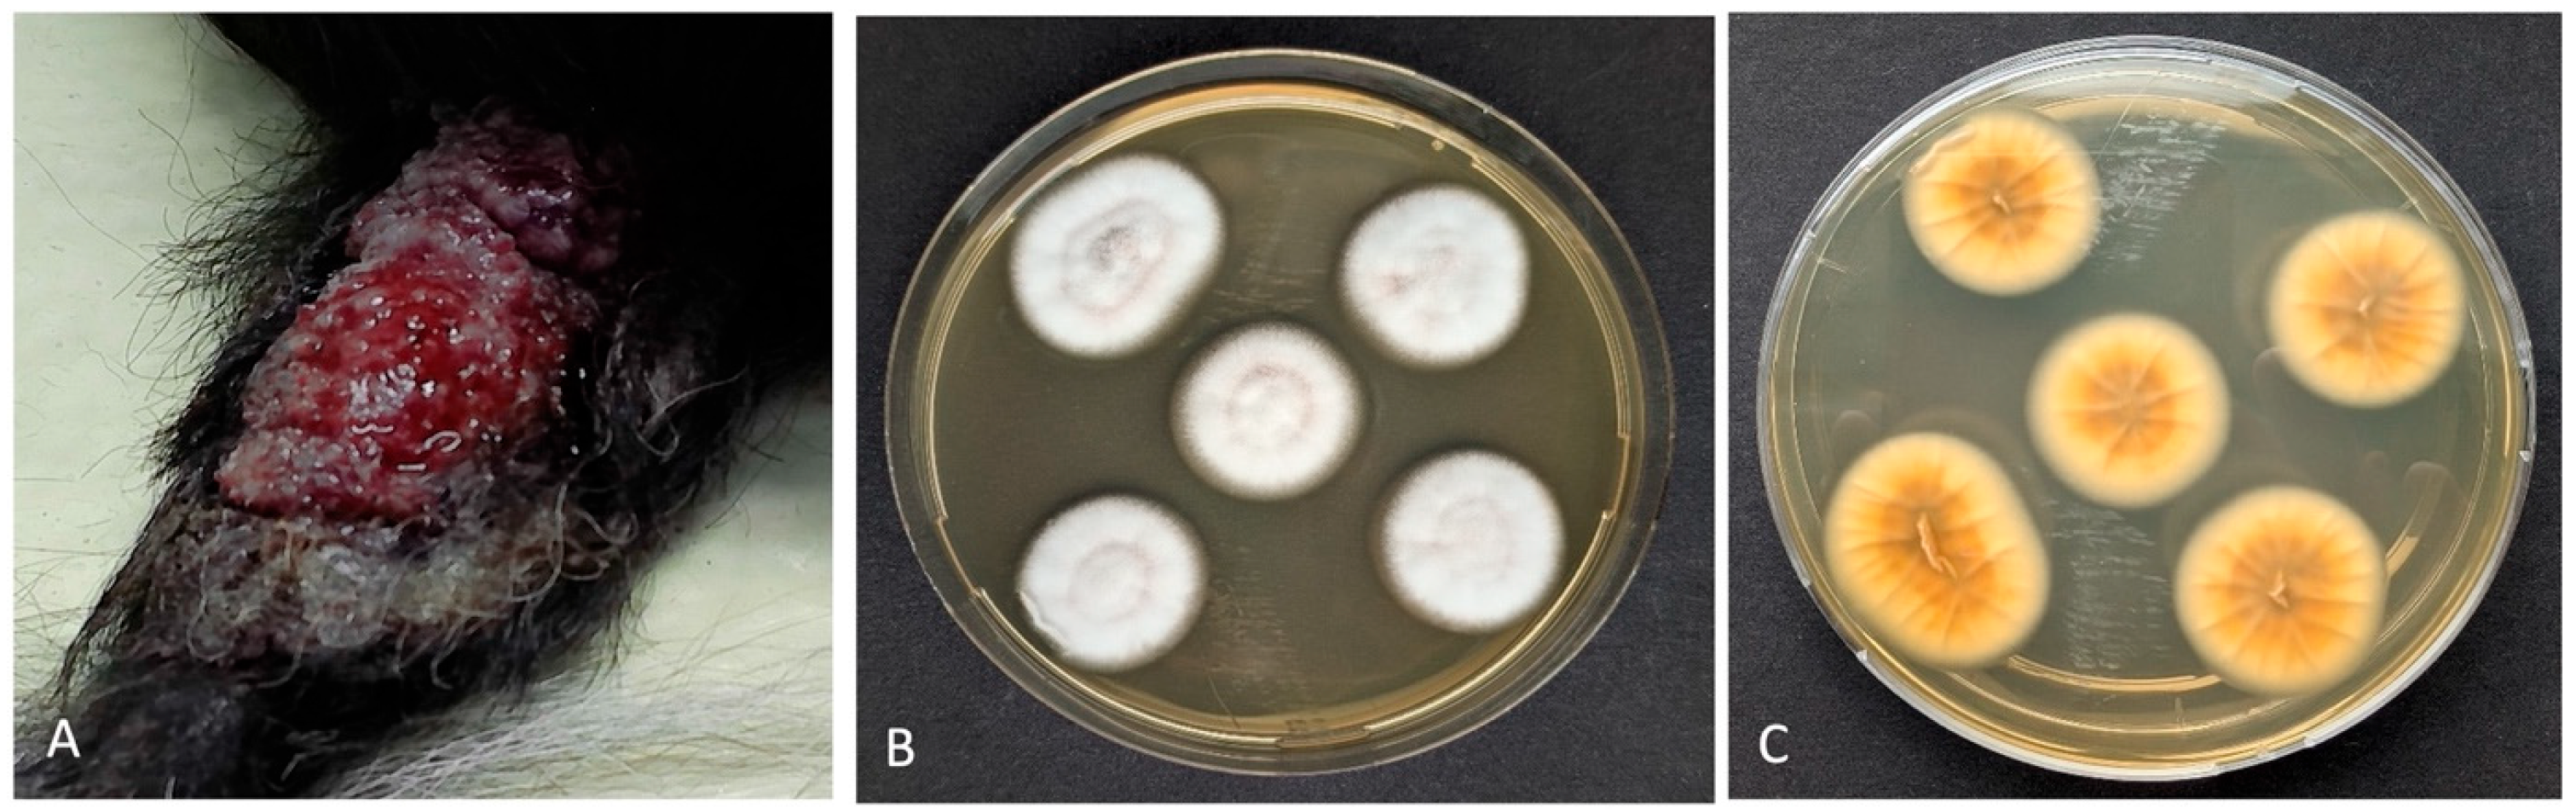
Vetsci 12 00958 g001 Vetsci 12 00958 g001

Deep Fungal Infection of the Skin with Two Rare Fungi in a Dog Being Treated with Immunosuppressant Therapy: A Case Report
Abstract
Simple Summary
Abstract
1. Background
2. Case Presentation
3. Discussion
4. Conclusions
Author Contributions
Funding
Institutional Review Board Statement
Informed Consent Statement
Data Availability Statement
Acknowledgments
Conflicts of Interest
Abbreviations
| MUO | Meningoencephalitis of Unknown Origin |
| PCR | Polymerase Chain Reaction |
| ITS | Internal Transcribed Spacer |
| EUCAST | European Confederation of Medical Mycology |
| MIC | Minimum Inhibitory Concentration |
| CT | Computed Tomography |
| ECMM | European Confederation of Medical Mycology |
| ISHAM | Internal Society for Human and Animal Mycology |
| ASM | American Society for Microbiology |
| CLSI | Clinical and Laboratory Standards Institute |
| ECOFF | Epidemiological Cut-Off Value |
References
- Heidemann, P.L.; Erhald, B.; Koch, B.C.; Gredal, H. Investigation of side effects to treatment and cause of death in 63 Scandinavian dogs suffering from meningoencephalitis of unknown origin: A retrospective study. Acta Vet. Scand. 2023, 65, 46. [Google Scholar] [CrossRef] [PubMed]
- Brady, S.; Woodward, A.; Le Chevoir, M. Survival time and relapse in dogs with meningoencephalomyelitis of unknown origin treated with prednisolone and ciclosporin: A retrospective study. Aust. Vet. J. 2020, 98, 491–498. [Google Scholar] [CrossRef] [PubMed]
- Al Kafaji, T.; Corda, A.; Biggio, F.; Gallucci, A. Cyclosporine and prednisolone treatment leads to fewer relapses compared with prednisolone alone in dogs with suspected meningomyelitis of unknown origin. J. Am. Vet. Med. Assoc. 2025, 27, 1–6. [Google Scholar] [CrossRef] [PubMed]
- Swann, J.W.; Garden, O.A.; Fellman, C.L.; Glanemann, B.; Goggs, R.; LeVine, D.N. ACVIM consensus statement on the treatment of immune-mediated hemolytic anemia in dogs. J. Vet. Intern. Med. 2019, 33, 1141–1172. [Google Scholar] [CrossRef]
- Barber, R.; Downey, K.L. Treatment with Cytarabine at Initiation of Therapy with Cyclosporine and Glucocorticoids for Dogs with Meningoencephalomyelitis of Unknown Origin Is Not Associated with Improved Outcomes. Front. Vet. Sci. 2022, 9, 925774. [Google Scholar] [CrossRef]
- Haynes, S.; Hodge, P.; Tyrrell, D.; Abraham, L. Disseminated Scedosporium prolificans infection in a German Shepherd dog. Aust. Vet. J. 2012, 90, 34–38. [Google Scholar] [CrossRef]
- McAtee, B.B.; Cummings, K.J.; Cook, A.K.; Lidbury, J.A.; Heseltine, J.C.; Willard, M.D. Opportunistic Invasive Cutaneous Fungal Infections Associated with Administration of Cyclosporine to Dogs with Immune-mediated Disease. J. Vet. Intern. Med. 2017, 31, 1724–1729. [Google Scholar] [CrossRef]
- Dowling, S.R.; Webb, J.; Foster, J.D.; Ginn, J.; Foy, D.S.; Trepanier, L.A. Opportunistic fungal infections in dogs treated with ciclosporin and glucocorticoids: Eight cases. J. Small Anim. Pract. 2016, 57, 105–109. [Google Scholar] [CrossRef]
- Dedeaux, A.; Grooters, A.; Wakamatsu-Utsuki, N.; Taboada, J. Opportunistic Fungal Infections in Small Animals. J. Am. Anim. Hosp. Assoc. 2018, 54, 327–337. [Google Scholar] [CrossRef]
- Jae-Ik, H.; Chang-Min, L.; In Lee, S.-Y.C.; Hee-Myung, P.; Taewoo, K. Pulmonary Candidiasis in a Dog Receiving Long-term Management for Atopic Dermatitis. J. Vet. Clin. 2015, 32, 259–262. [Google Scholar]
- Brennan, E.; Liatis, T.; Frosini, S.; Johnson, E.; Bond, R. Phaeohyphomycosis caused by Trematosphaeria grisea in an immunocompromised English springer spaniel. Vet. Rec. Case Rep. 2024, 12, e988. [Google Scholar] [CrossRef]
- Swift, I.; Griffin, A.; Shipstone, M. Successful treatment of disseminated cutaneous phaeohyphomycosis in a dog. Aust. Vet. J. 2006, 84, 431–435. [Google Scholar] [CrossRef] [PubMed]
- Rothenburg, L.S.; Snider, T.A.; Wilson, A.; Confer, A.W.; Ramachandran, A.; Mani, R. Disseminated phaeohyphomycosis in a dog. Med. Mycol. Case Rep. 2017, 15, 28–32. [Google Scholar] [CrossRef] [PubMed]
- Pawloski, D.R.; Brunker, J.D.; Singh, K.; Sutton, D.A. Pulmonary Paecilomyces lilacinus Infection in a Cat. J. Am. Anim. Hosp. Assoc. 2010, 46, 197–202. [Google Scholar] [CrossRef] [PubMed]
- Albert, R.; Lemaignen, A.; Desoubeaux, G.; Bailly, E.; Bernard, L.; Lacasse, M. Chronic subcutaneous infection of Purpureocillium lilacinum in an immunocompromised patient: Case report and review of the literature. Med. Mycol. Case Rep. 2022, 38, 5–8. [Google Scholar] [CrossRef]
- Rosser, E.J. Cutaneous Paecilomycosis in a Cat. J. Am. Anim. Hosp. Assoc. 2003, 39, 543–546. [Google Scholar] [CrossRef]
- Vennewald, I.; Wollina, U. Cutaneous infections due to opportunistic molds: Uncommon presentations. Clin. Dermatol. 2005, 23, 565–571. [Google Scholar] [CrossRef]
- Blaga, R.; Fabres, V.; Leynaud, V.; Fontaine, J.J.; Reyes-Gomez, E.; Briand, A. Toxoplasma gondii and Alternaria sp.: An Original Association in an Immunosuppressed Dog with Persistent Skin Lesions. Pathogens 2023, 12, 114. [Google Scholar] [CrossRef]
- Strzok, E.; Siepker, C.; Armwood, A.; Howerth, E.; Smith, J.; Banovic, F. Successful Treatment of Cutaneous Curvularia geniculata, Nocardia niigatensis, and Viral Papillomatosis in a Dog During the Therapeutic Management of Immune-Mediated Hemolytic Anemia. Front. Vet. Sci. 2019, 6, 249. [Google Scholar] [CrossRef]
- Dedola, C.; Stuart, A.P.G.; Ridyard, A.E.; Else, R.W.; Van Den Broek, A.H.M.; Choi, J.S. Cutaneous Alternaria infectoria infection in a dog in association with therapeutic immunosuppression for the management of immune-mediated haemolytic anaemia. Vet. Dermatol. 2010, 21, 626–634. [Google Scholar] [CrossRef]
- Sasaki, K.; Shimoda, M. Possible drug–drug interaction in dogs and cats resulted from alteration in drug metabolism: A mini review. J. Adv. Res. 2015, 6, 383–392. [Google Scholar] [CrossRef]
- Sousa, Y.V.; Santiago, M.G.; De Souza, B.M.; Keller, K.M.; Oliveira, C.S.F.; Mendoza, L. Itraconazole in human medicine and veterinary practice. J. Med. Mycol. 2024, 34, 101473. [Google Scholar] [CrossRef] [PubMed]
- Foy, D.S.; Trepanier, L.A. Antifungal Treatment of Small Animal Veterinary Patients. Vet. Clin. North. Am. Small Anim. Pract. 2010, 40, 1171–1188. [Google Scholar] [CrossRef] [PubMed]
- Alastruey-Izquierdo, A.; Melhem, M.S.C.; Bonfietti, L.X.; Rodriguez-Tudela, J.L. Susceptibility Test for Fungi: Clinical and Laboratorial Correlations in Medical Mycology. Rev. Inst. Med. Trop. São Paulo 2015, 57 (Suppl. 19), 57–64. [Google Scholar] [CrossRef] [PubMed]
- Hoenigl, M.; Salmanton-García, J.; Walsh, T.J.; Nucci, M.; Neoh, C.F.; Jenks, J.D. Global guideline for the diagnosis and management of rare mould infections: An initiative of the European Confederation of Medical Mycology in cooperation with the International Society for Human and Animal Mycology and the American Society for Microbiology. Lancet Infect. Dis. 2021, 21, e246–e257. [Google Scholar] [CrossRef]
- Aneke, C.; Otranto, D.; Cafarchia, C. Therapy and Antifungal Susceptibility Profile of Microsporum canis. J. Fungi 2018, 4, 107. [Google Scholar] [CrossRef]
- Guinea, J. Updated EUCAST Clinical Breakpoints against Aspergillus, Implications for the Clinical Microbiology Laboratory. J. Fungi 2020, 6, 343. [Google Scholar] [CrossRef]
- Pfaller, M.A.; Andes, D.; Diekema, D.J.; Espinel-Ingroff, A.; Sheehan, D. Wild-type MIC distributions, epidemiological cutoff values and species-specific clinical breakpoints for fluconazole and Candida: Time for harmonization of CLSI and EUCAST broth microdilution methods. Drug Resist. Updates 2010, 13, 180–195. [Google Scholar] [CrossRef]
- Guillet, J.; Berkaoui, I.; Gargala, G.; Gondé, H.; Tamarit, C.; Leclerc, J. Cutaneous Alternariosis. Mycopathologia 2024, 189, 81. [Google Scholar] [CrossRef]

Disclaimer/Publisher’s Note: The statements, opinions and data contained in all publications are solely those of the individual author(s) and contributor(s) and not of MDPI and/or the editor(s). MDPI and/or the editor(s) disclaim responsibility for any injury to people or property resulting from any ideas, methods, instructions or products referred to in the content. |
© 2025 by the authors. Licensee MDPI, Basel, Switzerland. This article is an open access article distributed under the terms and conditions of the Creative Commons Attribution (CC BY) license (https://creativecommons.org/licenses/by/4.0/).
Share and Cite
Suarez-Kupka, A.B.; Ehling, S.; Siesenop, U.; Verspohl, J.; Volk, A.V. Deep Fungal Infection of the Skin with Two Rare Fungi in a Dog Being Treated with Immunosuppressant Therapy: A Case Report. Vet. Sci. 2025, 12, 958. https://doi.org/10.3390/vetsci12100958
Suarez-Kupka AB, Ehling S, Siesenop U, Verspohl J, Volk AV. Deep Fungal Infection of the Skin with Two Rare Fungi in a Dog Being Treated with Immunosuppressant Therapy: A Case Report. Veterinary Sciences. 2025; 12(10):958. https://doi.org/10.3390/vetsci12100958
Chicago/Turabian StyleSuarez-Kupka, Aimara Bello, Sarah Ehling, Ute Siesenop, Jutta Verspohl, and Andrea Vanessa Volk. 2025. "Deep Fungal Infection of the Skin with Two Rare Fungi in a Dog Being Treated with Immunosuppressant Therapy: A Case Report" Veterinary Sciences 12, no. 10: 958. https://doi.org/10.3390/vetsci12100958
APA StyleSuarez-Kupka, A. B., Ehling, S., Siesenop, U., Verspohl, J., & Volk, A. V. (2025). Deep Fungal Infection of the Skin with Two Rare Fungi in a Dog Being Treated with Immunosuppressant Therapy: A Case Report. Veterinary Sciences, 12(10), 958. https://doi.org/10.3390/vetsci12100958
